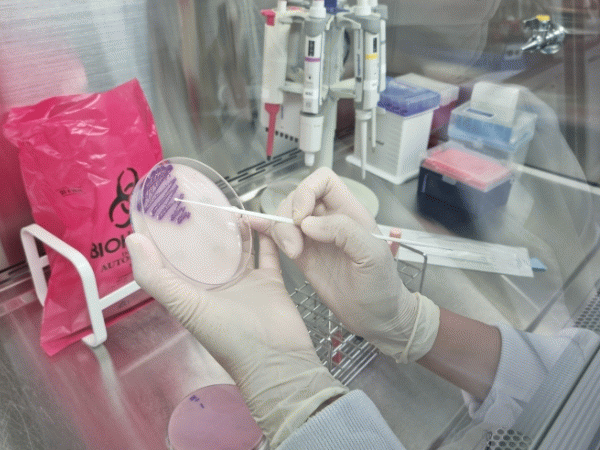

|
±¤ÁÖº¸°Çȯ°æ¿¬±¸¿øÀº Áúº´°ü¸®Ã» ÁÖ°üÀ¸·Î ¸ÅÁÖ Ç¥º»°¨½Ã ÀÇ·á±â°ü¿¡¼ ¼öÁýÇÑ Àå°ü°¨¿°Áõ, ¼öÁ·±¸º´ µî ¿£Å׷ιÙÀÌ·¯½º°¨¿°Áõ ÀǽÉȯÀÚ °Ëü·ÎºÎÅÍ ¿øÀκ´¿øÃ¼¸¦ ºÐ¼®ÇÏ´Â °¨½Ã»ç¾÷À» ¼öÇàÇϰí ÀÖ´Ù.
Àå°ü°¨¿°Áõ ¿øÀκ´¿øÃ¼ ºÐ¼® °á°ú, ¼¼±Õ¼ºº´¿øÃ¼ °ËÃâ·üÀº ¡ã6¿ù 35.1%(208°Ç Áß 73°Ç) ¡ã7¿ù 37.0%(192°Ç Áß 71°Ç) ¡ã8¿ù ù° ÁÖ 47.9%(48°Ç Áß 23°Ç)·Î Áõ°¡ÇßÀ¸¸ç, ÀÌÁß 96%(22°Ç)°¡ À庴¿ø¼º´ëÀå±Õ°ú »ì¸ð³Ú¶ó±ÕÀ¸·Î ³ªÅ¸³µ´Ù.
¼öÁ·±¸º´ °ËÃâ·üµµ 87.9%ÀÌ´ø 5¿ù ÀÌÈÄ ÁÖÃãÇÏ´Ù 7¿ù Áß¼øºÎÅÍ ´Ù½Ã Áõ°¡¼¼¸¦ º¸¿© 8¿ù ù° ÁÖ °ËÃâ·üÀÌ 100%(11°Ç Áß 11°Ç)·Î È®ÀεǴ µî Æø¿° ¼Ó ´Ù¾çÇÑ °¨¿°¼ºÁúȯÀÌ Áõ°¡Çϰí ÀÖ´Ù.
À庴¿ø¼º´ëÀå±ÕÀº ¿À¿°µÈ À°·ù³ª ä¼Ò, »ì¸ð³Ú¶ó±ÕÀº °è¶õ¡¤¿ìÀ¯¡¤À°·ù ¹× °¡°øÇ°ÀÌ ÁÖ¿ä °¨¿°¿øÀÌ´Ù. ÀÌµé ½ÄǰÀÇ º¸°ü, ¼ÕÁú, Á¶¸®¶§ ¼¼½ÉÇÑ ÁÖÀǰ¡ ÇÊ¿äÇÏ´Ù.
¼öÁ·±¸º´Àº ¿£Å׷ιÙÀÌ·¯½º °¨¿°¿¡ ÀÇÇÑ Áúº´À¸·Î ¼Õ°ú ¹ß, ÀԾȿ¡ ¹°ÁýÀÌ ÀâÈ÷¸ç °í¿°ú ÀÎÈÄÅëÀÌ ´ëÇ¥ Áõ»óÀÌ´Ù. ȯÀÚÀÇ ´ëº¯ ¶Ç´Â ºÐºñ¹°(¼öÆ÷, Áø¹° µî)°ú Á¢ÃËÇϰųª ¿À¿°µÈ Àå³°¨ µîÀ» ¸¸Áú °æ¿ì ½±°Ô °¨¿°µÈ´Ù.
¿©¸§Ã¶¿¡´Â ¿Âµµ°¡ ³ô°í ½À±â°¡ ¸¹¾Æ ¼¼±Õ Áõ½ÄÀÌ ºü¸£°Ô ÀϾ À½½Ä¹°À̳ª Á¶¸®È¯°æ À§»ý¿¡ ¼ÒȦÇÒ °æ¿ì Àå¿°¿¡ °É¸®±â ½±´Ù. ¶Ç ½Ç³» ¼ö¿µÀåÀ̳ª °è°î µî ¹°³îÀÌ È°µ¿ÀÌ ¸¹¾ÆÁö¸é¼ ¿£Å׷ιÙÀÌ·¯½º¿¡ ¿À¿°µÈ ¹°À̳ª ȯÀÚ¿Í Á¢ÃË µîÀ» ÅëÇØ ¼öÁ·±¸º´¿¡ °¨¿°µÉ ¼ö ÀÖ´Ù.
°°æ¸® ±¤ÁÖº¸°Çȯ°æ¿¬±¸¿ø ¼öÀμºÁúȯ°úÀåÀº ¡°¹«´õÀ§°¡ Áö¼ÓµÇ¸é¼ Àå¿°, ¼öÁ·±¸º´»Ó¸¸ ¾Æ´Ï¶ó ´«º´À̳ª ½ÄÁßµ¶ µî ´Ù¾çÇÑ °¨¿°¼ºÁúȯÀÇ ¹ß»ý À§ÇèÀÌ ³ô¾ÆÁö°í ÀÖ´Ù¡±¸ç ¡°¼Õ¾Ä±â µî °³ÀÎÀ§»ý°ú À½½Ä¹° °ü¸®¸¦ öÀúÈ÷ ÇØ¾ß ÇÑ´Ù¡±°í ¸»Çß´Ù.
±è¹ÌÀÚ ±âÀÚ
±è¹ÌÀÚ ±âÀÚÀÇ ´Ù¸¥ ±â»ç º¸±â

2025.11.24(¿ù) 15:27